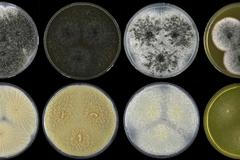
kolonie nové houby Aspergillus hubkae
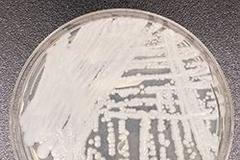
Candida auris

Bakterie v ústech jsou jako přírodní viagra. Pánové, žvýkejte salát, radí biolog
Schovejte si stolici do naší banky, může vás to zachránit před rakovinou, radí molekulární mikrobiolog Petr Ryšávka. V Brně založil speciální laboratoř, ve které lidem zamrazuje jejich vlastní exkrementy. „V budoucnu jim to může pomoci s obnovou přirozené střevní mikroflóry, která je rozhodující při obraně těla před nemocemi,“ vysvětluje v rozhovoru.